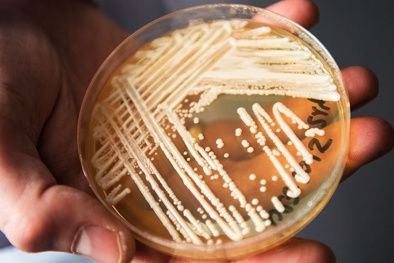
Mối đe dọa toàn cầu từ các loại nấm kháng thuốc

Năng suất Chất lượng
Chất lượng sống

Hệ tiện ích ‘all in one’ và kỳ nghỉ 'bất tận' của cư dân Blanca 6, 7
(VietQ.vn) - Nằm tại trung tâm Blanca City, chỉ cách biển Bãi Sau “vài bước chân”, 2 tòa tháp Blanca 6 và 7 không chỉ sở hữu tầm nhìn hai phía biển đắt giá mà còn mở ra không gian sống hiện đại, kết nối cộng đồng cư dân với chuỗi tiện ích đẳng cấp trong đại đô thị lớn bậc nhất Vũng Tàu.
-

Ecopark diễn tập phòng cháy chữa cháy quy mô lớn nhất từ trước tới nay
Thanh niên Việt Nam tham gia giải chạy để nói “KHÔNG” với bạo lực phụ nữ và trẻ em gái
Những loại rau chứa nhiều muối người cao huyết áp nên tránh
Nhân viên Prudential Việt Nam được nghỉ phép lên đến 30 ngày/năm
Nhận thức về giảm lượng nhựa sử dụng một lần và tăng cường quản lý rác tăng 40%
Hành trình cuộc sống - mang niềm vui đến trẻ em khó khăn TP.Hải Phòng
Nhận ngay cơ hội du lịch châu Âu khi mua bảo hiểm của Prudential
Tin mới Chất lượng sống 24h

Vì sao bất động sản thấp tầng Vinhomes luôn có thanh khoản tốt?
(VietQ.vn) - Sở hữu hàng loạt ưu thế vượt trội về trải nghiệm sống, hệ sinh thái có 1-0-2 cùng lịch sử tăng giá đáng mơ ước, bất động sản thấp tầng Vinhomes được đánh giá là khác biệt với phần còn lại của thị trường.

Sun World Ha Long mở cửa đón khách trải nghiệm Cáp treo Nữ Hoàng từ 21/11
(VietQ.vn) - Từ ngày 21/11, Cáp treo Nữ Hoàng thuộc Tổ hợp vui chơi giải trí số 1 Miền Bắc Sun World Ha Long chính thức đón khách trở lại. Nhân dịp này, Sun World Ha Long cũng dành tặng du khách nhiều trải nghiệm mới mẻ và ưu đãi đặc biệt chưa từng có.
Mối đe dọa toàn cầu từ các loại nấm kháng thuốc
(VietQ.vn) - Mới đây, WHO đã đưa ra cảnh báo về các loại nấm kháng thuốc và lan rộng toàn cầu gây nguy hiểm cho tính mạng người bệnh.

Mỗi năm Việt Nam có khoảng 200.000 người đột quỵ, những thực phẩm giúp ngăn ngừa hiệu quả
(VietQ.vn) - Đột quỵ là căn bệnh không lây nhiễm nhưng vô cùng nguy hiểm tới tính mạng nhưng vẫn có thể phòng chống bằng lối sống và ăn uống lành mạnh nhờ các loại thực phẩm quen thuộc.

Phát hiện mới: Trà bồ công anh có thể hỗ trợ tiêu diệt các tế bào ung thư
(VietQ.vn) - Theo nghiên cứu mới nhất tại Anh cho thấy, trà bồ công anh có thể hỗ trợ tiêu diệt các tế bào ung thư tuyến tụy, ung thư máu và cả ung thư đại tràng.

Sun Group và khát vọng kiến tạo hệ sinh thái du lịch đẳng cấp cho Việt Nam
(VietQ.vn) - Xây dựng hệ sinh thái du lịch đẳng cấp khắp ba miền đất nước, tiên phong kiến tạo thương hiệu vui chơi giải trí và nghỉ dưỡng đẳng cấp, góp phần đưa Việt Nam lên bản đồ du lịch quốc tế, đi đầu trong những xu thế bất động sản gắn với du lịch thời thượng nhất, 15 năm qua, Sun Group đã định hình một “thương hiệu kiến tạo và dẫn dắt xu hướng”.

Hạt hạnh nhân có thể giúp cải thiện sức khỏe đường ruột hiệu quả
(VietQ.vn) - Theo kết quả nghiên cứu, việc tiêu thụ hạt hạnh nhân có thể hỗ trợ, có tác dụng tích cực trong quá trình trao đổi chất của vi khuẩn có lợi trong đường ruột.

Dùng hành tây đúng cách để nhận được nhiều lợi ích cho sức khỏe
(VietQ.vn) - Hiện nay xuất hiện trào lưu dùng hành tây để 'lọc chất độc trong nhà' nở rộ trên TikTok. Các chuyên gia khuyến cáo, phương pháp không hiệu quả tránh làm theo. Vậy đâu mới là cách dùng đúng để có lợi cho sức khỏe?

Loại rau phổ biến ở Việt Nam giá rất rẻ có thể làm giảm nguy cơ mắc nhiều loại ung thư
(VietQ.vn) - Theo nhiều nghiên cứu cho thấy, rau cải xoong có thể chống lại hầu hết các loại ung thư phổ biến nhất hiện nay.

Khách hàng choáng ngợp khi nhận bàn giao nhà 'đẹp hơn resort'
(VietQ.vn) - Với tiến độ thi công thần tốc, gần 1000 căn thuộc phân khu Chà Là (Vinhomes Ocean Park 2 – The Empire) đã được bàn giao tới tay khách hàng trong những ngày cuối năm. Tại sự kiện chào đón cư dân mới, nhiều người tỏ ra rất bất ngờ khi nơi mình sống đẹp không thua gì các resort đẳng cấp.

Những loại quả người lớn tuổi nên hạn chế sử dụng
(VietQ.vn) - Theo các chuyên gia dinh dưỡng, một số loại quả không thích hợp với người cao tuổi có các cơ quan nội tạng đang dần suy yếu.

Trường Cao đẳng Công thương Việt Nam: Tiếp tục đổi mới, nỗ lực hơn nữa để hoàn thành mục tiêu
(VietQ.vn) - Ngày 20/11/2022, Trường Cao đẳng Công thương Việt Nam (VCI) đã long trọng tổ chức Lễ tổng kết năm học 2021 - 2022, khai giảng năm học 2022 - 2023 và kỷ niệm 40 năm ngày Nhà giáo Việt Nam (20/11/1982 - 20/11/2022).

Nghiên cứu ra loại vaccine đầu tiên có thể điều trị u não ác tính
(VietQ.vn) - Các nhà khoa học Anh đã nghiên cứu ra loại vaccine đầu tiên trên thế giới có thể điều trị u não ác tính, giúp bệnh nhân sống thêm nhiều năm.

Viettel TV360 có bản quyền tiếp sóng đầy đủ 64 trận World Cup 2022
(VietQ.vn) - Ngày 19/11/2022, Tổng Công ty Viễn thông Viettel công bố dịch vụ truyền hình Viettel TV360 đã chính thức có bản quyền tiếp phát sóng toàn bộ giải đấu World Cup 2022 trên lãnh thổ Việt Nam, sẵn sàng đem đến những trải nghiệm đỉnh cao, sôi động cho người hâm mộ bộ môn thể thao vua.

Những lời chúc hay và ý nghĩa nhân ngày Nhà giáo Việt Nam 20/11
(VietQ.vn) - Những lời chúc hay và ý nghĩa gửi tới thầy cô nhân ngày Nhà giáo Việt Nam 20/11 là món quà tinh thần vô giá. Với thầy cô giáo, không có món quà nào quý giá hơn là sự trưởng thành, nên người của các thế hệ học sinh.

Những loại vi khuẩn có thể gây bệnh tiềm ẩn trong món sashimi
(VietQ.vn) - Sashimi không còn xa lạ thậm chí là món ăn ưa thích của rất nhiều người. Tuy vậy, đằng sau đó là những ẩn họa khó lường do có thể bị nhiễm nhiều vi khuẩn gây bệnh.

Nghiên cứu loại thuốc 'siêu mạnh' có khả năng tiêu diệt virus gây sốt xuất huyết trong 6 giờ
(VietQ.vn) - Các nhà nghiên cứu tại trường Đại học quốc gia Singapore đang tiến hành thử nghiệm lâm sàng loại thuốc có thể tiêu diệt được virus sốt xuất huyết.

Đón mùa lễ hội cuối năm, Vietjet tặng ngay voucher đến 500.000 đồng cho khách hàng
(VietQ.vn) - Tưng bừng cùng Vietjet chào đón khách hàng thứ 150 triệu, sẵn sàng với mùa lễ hội cuối năm, tất cả khách hàng sẽ nhận ngay voucher với giá trị lên tới 500.000 đồng áp dụng dễ dàng trên toàn mạng bay với thời gian bay linh hoạt.

8 hạng mục giải thưởng World Travel Awards 2022 gọi tên các công trình của Sun Group
(VietQ.vn) - Tối 11/11/2022, trong khuôn khổ Lễ trao Giải thưởng Du lịch Thế giới World Travel Awards 2022 diễn ra tại Vương quốc Oman, Sun Group tiếp tục khẳng định vị thế du lịch Việt qua những giải thưởng danh giá cho các công trình dọc khắp 3 miền đất nước.

Đồ uống chứa quá nhiều đường có thể dẫn đến cục máu đông đe dọa tính mạng
(VietQ.vn) - Theo Hiệp hội Tim mạch Mỹ, đồ uống chứa nhiều đường có thể làm tăng nguy cơ xơ vữa động mạch - làm dày hoặc cứng các động mạch - từ đó có thể dẫn đến cục máu đông.
















